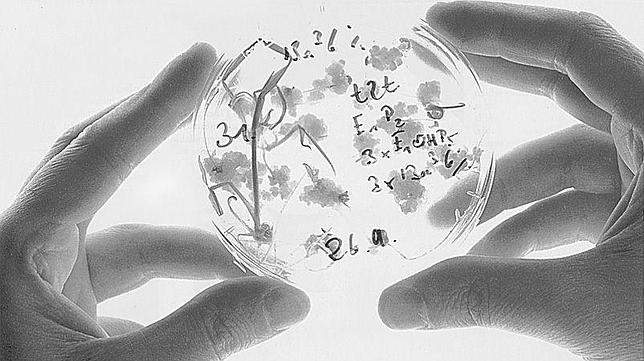
Investigadores españoles desarrollan un nuevo método para convertir el azúcar en energía

Investigadores españoles desarrollan un nuevo método para convertir el azúcar en energía
Científicos del CSIC y de la UPV han diseñado catalizadores inorgánicos, más baratos y resistentes que los biológicos que se utilizan en la actualidad
efe
Científicos españoles del Instituto de Tecnología Química, centro mixto del Consejo Superior de Investigaciones Científicas (CSIC) y de la Universidad Politécnica de Valencia , han formado parte de una investigación internacional en la que han logrado fabricar unos catalizadores artificiales que ... pueden sustituir a los biológicos -mucho más sensibles y caros de obtener- y que son capaces de transformar los azúcares en energía.
Estos catalizadores permitirían fabricar productos químicos, plásticos y combustibles procedentes de la biomasa (materia orgánica rica en azúcares) de manera más eficiente.
Un momento clave en la producción de gran parte de estos productos químicos de alto valor añadido es la «isomerización» o transformación de la glucosa en fructosa , un azúcar que presenta una reactividad mucho mayor que la glucosa.
Se podrán fabricar químicos y combustibles de biomasa de forma más eficiente
Actualmente, esta reacción se lleva a cabo utilizando un catalizador biológico (enzima). Sin embargo, estas enzimas presentan grandes problemas de operatividad (exigen purificaciones previas, unas condiciones de pH determinadas y sólo soportan temperaturas limitadas ), unos requisitos que hacen imposible su uso en gran parte de los procesos químicos o que los encarecen demasiado. «Este proceso transformador de glucosa a fructosa es el mayor proceso biocatalítico mundial para la producción de jarabe de fructosa, el cual se utiliza como edulcorante en multitud de refrescos . Un proceso enzimático que se realiza a temperaturas ambientales y pHs muy neutros», ha explicado el investigador del CSIC Manuel Moliner.
Sin embargo, si se quieren utilizar en otras reacciones para obtener químicos de alto valor añadido, «no es viable utilizar estas enzimas porque las condiciones de trabajo necesarias, como por ejemplo altas temperaturas, las destruirían», puntualiza Moliner.
Nuevos desafíos
Por eso, uno de los grandes desafíos actuales es saber cómo actúan los sistemas biológicos, y ser capaces de diseñar catalizadores artificiales más eficientes y estables que los sustituyan, subraya Moliner.
«Lo que nosotros hemos conseguido es transformar la glucosa en fructosa usando un catalizador inorgánico (una zeolita) con centros aislados metálicos, que mimetizan el comportamiento del catalizador biológico, lo que permite reproducir el proceso biológico en condiciones de temperatura o acidez mucho más extremas », apunta.
«Este procedimiento es muy interesante a nivel industrial, ya que nos permitiría obtener de manera eficiente productos químicos y combustibles derivados de la biomasa sin dañar el catalizador», concluye el investigador.
En la investigación, liderada por el Instituto Tecnológico de California , también han participado científicos del Laboratorio Nacional Argonne, de la Universidad del Noroeste de Evanston, de la Universidad del Estado de Wayne en Detroit, del Instituto Tecnológico de Massachusetts y del Centro para la Ciencia y la Tecnología Catalítica de Delaware. Los resultados de su trabajo se publicarán este lunes en la revista Proceedings of the National Academy of Sciences (PNAS).
Esta funcionalidad es sólo para suscriptores
Suscribete
Esta funcionalidad es sólo para registrados
Iniciar sesiónEsta funcionalidad es sólo para suscriptores
Suscribete